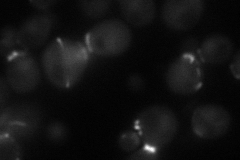
YMR032W
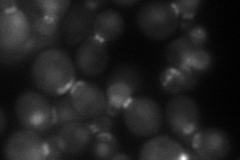
YMR032W
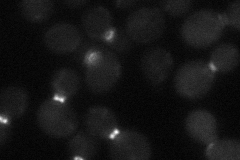
YMR032W
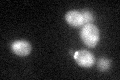
YMR032W

View description
Bud neck-localized, SH3 domain-containing protein required for cytokinesis; regulates actomyosin ring dynamics and septin localization; interacts with the formins, Bni1p and Bnr1p, and with Cyk3p, Vrp1p, and Bni5p
Localization:
Intensity:
Fold change:
Significance:
-
C’ GFP library in SD

bud neckN/A -
N' NOP1pr-GFP in SD
bud neck43.9242 -
N' TEF2pr-mCherry in SD
bud neck51.5698 -
N' NATIVEpr-GFP in SD
bud neck24.9206 -
N' TEF2pr-VC and Cyto-VN in SD

bud neck27.7016 -
C’ GFP library in SD+DTT
bud neck18.670.95No -
C’ GFP library in SD+H2O2

bud neck23.591.21No -
C’ GFP library in Starvation Media

cytosol15.420.79No -
C’ GFP library on the background of Pup2-DaMP

bud neck -
C’ GFP library on the background of CCT mutant

bud neck21.63421.10992No
